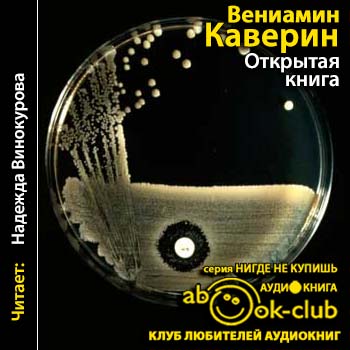

Формат: аудиоспектакль, MP3, 192kbps
Автор: Каверин Вениамин
Год выпуска: 1987
Жанр: Современная проза
Издательство: Радио Культура
Исполнитель: Елена Шанина, Дмитрий Брусникин и др.
Продолжительность: 05:16:02
Описание: Радиопостановка по одноименному произведению Вениамина Каверина. Автор прослеживает жизненный путь молодого ученого Татьяны Власенковой. Путь, на котором есть все: радость дружбы и боль предательства, счастье любви и пламя ненависти, разруха войны и тепло родного дома, борьба за свою мечту. Путь, приведший отважного ученого к важному научному открытию, оказавшему большое влиян ...
Лучшее в категории - Аудиокниги / Отечественная проза ХХ века
03
мар
2016
мар
2016
Открытая книга (Вениамин Каверин) [2016, Современная проза, аудиокнига, MP3, 96kbps, Надежда Винокурова]
Формат: аудиокнига, MP3, 96kbps
Формат: аудиокнига, MP3, 96kbps Автор: Вениамин Каверин
Год выпуска: 2016
Жанр: Современная проза
Издательство: Нигде не купишь
Исполнитель: Надежда Винокурова
Продолжительность: 29:12:53
Описание: Роман-трилогия рассказывает о молодом ученом Татьяне Власенковой, работающей в области микробиологии. Писатель прослеживает нелегкий, но мужественный путь героини к научному открытию, которое оказало глубокое влияние на развитие медицинской науки. Становление характера, судьба женщины-ученого дает плодотворный материал для осмысления современной молодежью жизненных идеалов.
Прототипом Татьяны Власенковой послужила выдающаяся советская ученая-микробиолог и эпидемиолог, создательница антибиотиков в СССР, Академик, действительный член АМН СССР, лауреат Сталинской премии, директор Института биологической профилактики инфекций, заслуженный деятель науки РСФСР Зинаида Виссарионовна Ермольева (1898 — 1974), которая в первом браке была замужем за советским ученым-иммунологом и вирусологом, старшим братом В. Каверина - Львом Зильбером.
В 2013 году, этот роман был включен в список «100 книг», рекомендованных школьникам Министерством образования и науки РФ для самостоятельного чтения. Роман был дважды экранизирован, по нему ставились многочисленные спектакли в театрах СССР.
Доп. информация: Релиз Клуба Любителей Аудиокниг
Прочитано по изданию: Собрание сочинений. В 8 томах. Тома 4 и 5, М.: "Художественная литература", 1981,1982г.
Очищено: knigofil
Обработано: knigofil
Обложка: Вася с Марса
12
фев
2012
фев
2012
Открытая книга мудрости (Х. Рэй) [2000, Психология, Философия, PDF, eBook (изначально компьютерное)]

Формат: PDF, eBook (изначально компьютерное)
Автор: Х. Рэй
Год выпуска: 2000
Жанр: Психология, Философия
Издательство: New Planet Publishing Co.
Язык: Русский
Количество страниц: 102
Описание: ВНИМАНИЕ! Прочтение этой информации имеет следующие последствия: 1. Ваше мировоззрение – все то, в чем Вы были убеждены до сих пор, пошатнется. Этот процесс можно назвать “разрушением ментального каркаса”, или просто обесцениванием многого из того, что вы знаете. 2. На некоторое время Вы станете менее уверены в себе, в своих действиях, в правильности своих мыслей и суждений. И для того, чтобы хотя бы во ...
Автор: Х. Рэй
Год выпуска: 2000
Жанр: Психология, Философия
Издательство: New Planet Publishing Co.
Язык: Русский
Количество страниц: 102
Описание: ВНИМАНИЕ! Прочтение этой информации имеет следующие последствия: 1. Ваше мировоззрение – все то, в чем Вы были убеждены до сих пор, пошатнется. Этот процесс можно назвать “разрушением ментального каркаса”, или просто обесцениванием многого из того, что вы знаете. 2. На некоторое время Вы станете менее уверены в себе, в своих действиях, в правильности своих мыслей и суждений. И для того, чтобы хотя бы во ...
07
апр
2015
апр
2015
Открытая дверь (Рэнкин Иэн) [2015, Детектив, аудиокнига, MP3, 96kbps, Кирсанов Сергей]

Формат: аудиокнига, MP3, 96kbps
Автор: Рэнкин Иэн
Год выпуска: 2015
Жанр: Детектив
Издательство: Нигде не купишь
Исполнитель: Кирсанов Сергей
Продолжительность: 12:39:24
Описание: Майк Маккензи удачно продал свою компьютерную фирму и мечтает заняться чем-нибудь действительно захватывающим. Его выбор падает на искусство, и когда профессор Роберт Гиссинг предлагает ему план безупречного преступления, Майк решает воплотить его в жизнь. Из-за нехватки места в Шотландской национальной галерее многие ценные произведения хранятся на складе в Грантоне. В «день открытых дверей» их можно похитить, а с п ...
Автор: Рэнкин Иэн
Год выпуска: 2015
Жанр: Детектив
Издательство: Нигде не купишь
Исполнитель: Кирсанов Сергей
Продолжительность: 12:39:24
Описание: Майк Маккензи удачно продал свою компьютерную фирму и мечтает заняться чем-нибудь действительно захватывающим. Его выбор падает на искусство, и когда профессор Роберт Гиссинг предлагает ему план безупречного преступления, Майк решает воплотить его в жизнь. Из-за нехватки места в Шотландской национальной галерее многие ценные произведения хранятся на складе в Грантоне. В «день открытых дверей» их можно похитить, а с п ...
26
ноя
2010
ноя
2010
Серия: "Книга-загадка, книга-мистика" (51 книга) [2009-2010, мистика, FB2, RTF, eBook (изначально компьютерно

Формат: FB2, RTF, eBook (изначально компьютерное)
Год выпуска: 2009-2010
Жанр: мистика
Издательство: Эксмо
Количество книг: 51
Описание: Серия начала издаваться в 2009 году параллельно с выходящей в том же издательстве в схожем оформлении серией «Книга-загадка, книга-бестселлер». Основная направленность — остросюжетные мистические произведения зарубежных авторов. В большинстве случаев это переиздания романов и авторских сборников, выходивших на русском языке ранее. Всего пока издана 41 книга, серия продолжается. В плену у призраков Где грань между сном и явью? Возможно ли, чтобы призрак пр ...
Год выпуска: 2009-2010
Жанр: мистика
Издательство: Эксмо
Количество книг: 51
Описание: Серия начала издаваться в 2009 году параллельно с выходящей в том же издательстве в схожем оформлении серией «Книга-загадка, книга-бестселлер». Основная направленность — остросюжетные мистические произведения зарубежных авторов. В большинстве случаев это переиздания романов и авторских сборников, выходивших на русском языке ранее. Всего пока издана 41 книга, серия продолжается. В плену у призраков Где грань между сном и явью? Возможно ли, чтобы призрак пр ...
08
ноя
2018
ноя
2018
Российские Пропилеи. Открытая структура: Якобсон-Бахтин-Лотман-Гаспаров (Автономова Н. С.) [2014, Философия, PDF/DjVu]

ISBN: 978-5-98712-156-6
Серия: Российские Пропилеи
Формат: PDF/DjVu
Качество: Отсканированные страницы + слой распознанного текста
Автор: Автономова Н. С.
Год выпуска: 2014
Жанр: Философия
Издательство:
СПб.: Центр гуманитарных инициатив (2-е изд., испр. и доп.)
Язык: Русский
Количество страниц: 509
Описание: «Открытая структура» — это парадокс, многозначная метафора, которая обнаруживает и свои познавательные возможности: она становится условием междисциплинарных переходов, местом выработки культурных и эпистемологических соизмеримостей. По образованию автор - философ и филолог, а потому эти ...
Серия: Российские Пропилеи
Формат: PDF/DjVu
Качество: Отсканированные страницы + слой распознанного текста
Автор: Автономова Н. С.
Год выпуска: 2014
Жанр: Философия
Издательство:
СПб.: Центр гуманитарных инициатив (2-е изд., испр. и доп.)
Язык: Русский
Количество страниц: 509
Описание: «Открытая структура» — это парадокс, многозначная метафора, которая обнаруживает и свои познавательные возможности: она становится условием междисциплинарных переходов, местом выработки культурных и эпистемологических соизмеримостей. По образованию автор - философ и филолог, а потому эти ...
27
мар
2018
мар
2018
Мефодий Буслаев: Книга семи дорог (16 книга) (Дмитрий Емец) [2017, Фэнтези, ЛитРес, аудиокнига, MP3, 53-58kbps [VBR], Михаил Назаренко]

Формат: аудиокнига, MP3, 53-58kbps [VBR]
Автор: Дмитрий Емец
Год выпуска: 2017
Жанр: Фэнтези, ЛитРес
Издательство: ЛитРес
Исполнитель: Михаил Назаренко
Продолжительность: 10:29:44
Описание: Давным-давно три сильнейших темных мага создали собственный мир – Книгу Семи Дорог – и заключили в него свои эйдосы. Поселившись в новой реальности, маги получили абсолютную власть и неуязвимость. Однако, чтобы жить вечно, они должны периодически заманивать к себе семь добровольцев. Попавшие в книгу навсегда забывают прошлое и воспринимают любого встречного как врага. Именно на этот артефакт и сделал ставку ...
Автор: Дмитрий Емец
Год выпуска: 2017
Жанр: Фэнтези, ЛитРес
Издательство: ЛитРес
Исполнитель: Михаил Назаренко
Продолжительность: 10:29:44
Описание: Давным-давно три сильнейших темных мага создали собственный мир – Книгу Семи Дорог – и заключили в него свои эйдосы. Поселившись в новой реальности, маги получили абсолютную власть и неуязвимость. Однако, чтобы жить вечно, они должны периодически заманивать к себе семь добровольцев. Попавшие в книгу навсегда забывают прошлое и воспринимают любого встречного как врага. Именно на этот артефакт и сделал ставку ...
25
мая
2018
мая
2018
Малазанская Книга Павших: Сады Луны (1 книга из 10) (Стивен Эриксон) [2018, Фэнтези, аудиокнига, M4В, 128kbps, Кирилл Головин]

Формат: аудиокнига, M4В, 128kbps
Автор: Стивен Эриксон
Год выпуска: 2018
Жанр: Фэнтези
Издательство: Аудиокнига своими руками
Исполнитель: Кирилл Головин
Продолжительность: 23:56:59
Описание: Огромный мир, в котором выше всего ценятся две доблести, две силы — власть мага и боевое искусство воителя. Могущественнейшая Империя подавлена властью новой Императрицы - узурпатора, бывшей главы Ордена убийц-ассасинов. Войска, принявшие сторону новой Повелительницы, захватывают одни за другим Свободные Города, но принуждены отступить перед могуществом таинственной Алой Гвардии воинов-магов. Бесконечная ...
Автор: Стивен Эриксон
Год выпуска: 2018
Жанр: Фэнтези
Издательство: Аудиокнига своими руками
Исполнитель: Кирилл Головин
Продолжительность: 23:56:59
Описание: Огромный мир, в котором выше всего ценятся две доблести, две силы — власть мага и боевое искусство воителя. Могущественнейшая Империя подавлена властью новой Императрицы - узурпатора, бывшей главы Ордена убийц-ассасинов. Войска, принявшие сторону новой Повелительницы, захватывают одни за другим Свободные Города, но принуждены отступить перед могуществом таинственной Алой Гвардии воинов-магов. Бесконечная ...
25
апр
2017
апр
2017
Книга магии для начинающих с нуля. Книга 1 (Кобасири Какэру) [2017, Фэнтези, аудиокнига, MP3, 128kbps, Adrenalin28]

Формат: аудиокнига, MP3, 128kbps
Автор: Кобасири Какэру
Год выпуска: 2017
Жанр: Фэнтези
Перевод: krass09 (RuRanobe)
Издательство: Аудиокнига своими руками
Исполнитель: Adrenalin28
Продолжительность: 07:48:25
Описание: Ведьмы. Загадочные существа, сказками о которых пугают непослушных детей. Способные творить необъяснимое колдовство, они всегда были гонимы Церковью и простым народом. Но что предпримут все эти люди, когда узнают о магии — силе пока неизвестной, но куда более опасной, чем ведьмовское колдовство? Он — зверочеловек-наемник, который ненавидит ведьм и свою сущность. Она — ведьма, отп ...
Автор: Кобасири Какэру
Год выпуска: 2017
Жанр: Фэнтези
Перевод: krass09 (RuRanobe)
Издательство: Аудиокнига своими руками
Исполнитель: Adrenalin28
Продолжительность: 07:48:25
Описание: Ведьмы. Загадочные существа, сказками о которых пугают непослушных детей. Способные творить необъяснимое колдовство, они всегда были гонимы Церковью и простым народом. Но что предпримут все эти люди, когда узнают о магии — силе пока неизвестной, но куда более опасной, чем ведьмовское колдовство? Он — зверочеловек-наемник, который ненавидит ведьм и свою сущность. Она — ведьма, отп ...
11
апр
2013
апр
2013
Стервятники: книга 1 "Мертвый сезон"; книга 2 "Стая" (Кетчам Джек) [2013, Ужасы, аудиокнига, AAC, 128kbps, M4B, Владимир Князев]

Формат: аудиокнига, AAC, 128kbps
Автор: Кетчам Джек
Год выпуска: 2013
Жанр: Ужасы
Издательство: Творческая группа "СамиЗдат"
Исполнитель: Владимир Князев
Продолжительность: 16:44:10
Описание: В серии «Стервятники» отразилась жестокая реальность наших дней, перед которой меркнут самые жуткие мистические сказки прошлого. Несколько поколений кровожадных дикарей, поселившихся в пещерах американского штата Мэн и промышляющих людоедством – какая сила способна остановить их жажду крови? Кто может бросить вызов чудовищной страсти охотников за человеческой плотью? Вполне возможно, что «Стервятники» яв ...
Автор: Кетчам Джек
Год выпуска: 2013
Жанр: Ужасы
Издательство: Творческая группа "СамиЗдат"
Исполнитель: Владимир Князев
Продолжительность: 16:44:10
Описание: В серии «Стервятники» отразилась жестокая реальность наших дней, перед которой меркнут самые жуткие мистические сказки прошлого. Несколько поколений кровожадных дикарей, поселившихся в пещерах американского штата Мэн и промышляющих людоедством – какая сила способна остановить их жажду крови? Кто может бросить вызов чудовищной страсти охотников за человеческой плотью? Вполне возможно, что «Стервятники» яв ...
13
мая
2017
мая
2017
Книжная серия - Книга-фантазия (41 книга из 49) [2010 - 2016, Фэнтези, FB2, eBook (изначально компьютерное)]

ISBN: Книга-фантазия
Формат: FB2, eBook (изначально компьютерное)
Автор: разные
Год: 2010 - 2016
Жанр: Фэнтези
Издательство: Эксмо, Домино
Язык: Русский
Количество книг: 41 из 49
Описание: Изначально задуманная как персональная серия Джеймса Клеменса для его произведений, созданных в жанре фэнтези, «Книга-фантазия» стала в мае 2011 года очередной серией для издания фэнтезийных историй разных авторов. Однако, в отличие от предыдущих подобных серий в «Книге-фантазии» издаются только избранные авторы с уровнем текстов, как минимум, выше среднего. С момента прекращения сотрудничества с издательст ...
Формат: FB2, eBook (изначально компьютерное)
Автор: разные
Год: 2010 - 2016
Жанр: Фэнтези
Издательство: Эксмо, Домино
Язык: Русский
Количество книг: 41 из 49
Описание: Изначально задуманная как персональная серия Джеймса Клеменса для его произведений, созданных в жанре фэнтези, «Книга-фантазия» стала в мае 2011 года очередной серией для издания фэнтезийных историй разных авторов. Однако, в отличие от предыдущих подобных серий в «Книге-фантазии» издаются только избранные авторы с уровнем текстов, как минимум, выше среднего. С момента прекращения сотрудничества с издательст ...
04
сен
2018
сен
2018
Малазанская Книга Павших: Врата дома смерти (2 книга из 10) (Стивен Эриксон) [2018, Фэнтези, аудиокнига, MP3, 128kbps, Кирилл Головин]

Формат: аудиокнига, MP3, 128kbps
Автор: Стивен Эриксон
Год выпуска: 2018
Жанр: Фэнтези
Издательство: Аудиокнига своими руками
Исполнитель: Кирилл Головин
Продолжительность: 31:19:00
Описание: Семь городов… Древний континент, история которого теряется в глубинах тысячелетий. Завоевав его, малазанцы никогда не относились всерьез к легендам и верованиям местных племен. Власть Империи в Семи городах казалась им незыблемой, а пророчества о Дриджне, священном возмездии, – очередными слухами. Вплоть до страшной ночи, когда слухи вдруг превратились в зловещую реальность. Оправившись от «семиградского ...
Автор: Стивен Эриксон
Год выпуска: 2018
Жанр: Фэнтези
Издательство: Аудиокнига своими руками
Исполнитель: Кирилл Головин
Продолжительность: 31:19:00
Описание: Семь городов… Древний континент, история которого теряется в глубинах тысячелетий. Завоевав его, малазанцы никогда не относились всерьез к легендам и верованиям местных племен. Власть Империи в Семи городах казалась им незыблемой, а пророчества о Дриджне, священном возмездии, – очередными слухами. Вплоть до страшной ночи, когда слухи вдруг превратились в зловещую реальность. Оправившись от «семиградского ...
02
июн
2014
июн
2014
Сказки кота Мурлыки. Красная книга. Синяя книга (Эме Марсель) [2012, Сказки, аудиокнига, MP3, 128kbps, Кирилл Петров]

Формат: аудиокнига, MP3, 128kbps
Автор: Эме Марсель
Год выпуска: 2012
Жанр: Сказки
Издательство: Нигде не купишь
Исполнитель: Кирилл Петров
Продолжительность: 08:01:06
Описание: Известному французскому писателю Марселю Эме блестяще удавались не только серьезные книги для взрослых, но и детские произведения. Критики называют его продолжателем традиций Лафонтена и Шарля Перро, а "Сказки кота Мурлыки" давно стали классикой детской литературы. Во всем мире и дети, и взрослые с удовольствием читают эти добрые истории о сестренках Дельфине и Маринетте и их друзьях, животных с фермы. По традиции, ска ...
Автор: Эме Марсель
Год выпуска: 2012
Жанр: Сказки
Издательство: Нигде не купишь
Исполнитель: Кирилл Петров
Продолжительность: 08:01:06
Описание: Известному французскому писателю Марселю Эме блестяще удавались не только серьезные книги для взрослых, но и детские произведения. Критики называют его продолжателем традиций Лафонтена и Шарля Перро, а "Сказки кота Мурлыки" давно стали классикой детской литературы. Во всем мире и дети, и взрослые с удовольствием читают эти добрые истории о сестренках Дельфине и Маринетте и их друзьях, животных с фермы. По традиции, ска ...
21
ноя
2010
ноя
2010
Книга-загадка, книга-бестселлер (127 книг) [2005-2011,интеллектуальный детектив, RTF, FB2, eBook (изначально ко]

Серия: Книга-загадка, книга-бестселлер
Формат: RTF, FB2, eBook (изначально компьютерное)
Год выпуска: 2005-2011
Жанр: интеллектуальный детектив
Издательство: Эксмо, Домино
Количество книг: 127
Описание: Романы, вошедшие в эту серию, удачно сочетают в себе детективный сюжет и элементы мистики, философии, истории и религии, что сделало их прекрасными объектами для экранизации. Они полны интриг и загадок, связанных с историей становления христианства, крестовыми походами, мальтийским орденом и тамплиерами, средневековой жизнью Европы. Например, в романе Кэтрин Нэвилл «Магический круг» старинные ...
Формат: RTF, FB2, eBook (изначально компьютерное)
Год выпуска: 2005-2011
Жанр: интеллектуальный детектив
Издательство: Эксмо, Домино
Количество книг: 127
Описание: Романы, вошедшие в эту серию, удачно сочетают в себе детективный сюжет и элементы мистики, философии, истории и религии, что сделало их прекрасными объектами для экранизации. Они полны интриг и загадок, связанных с историей становления христианства, крестовыми походами, мальтийским орденом и тамплиерами, средневековой жизнью Европы. Например, в романе Кэтрин Нэвилл «Магический круг» старинные ...
06
мая
2016
мая
2016
Серия - Книга-загадка, книга-бестселлер [2005-2016, Интеллектуальная проза, детектив, триллер, FB2, OCR без ошибок]

Серия - "Книга-загадка, книга-бестселлер"
Серия: Книга-загадка, книга-бестселлер
Формат: FB2, OCR без ошибок
Автор: разные
Год выпуска: 2012-2016
Жанр: Интеллектуальная проза, детектив, триллер
Издательство: Эксмо
Язык: русский
Количество книг: 211
Описание: "Книга-загадка, книга-бестселлер" Романы, вошедшие в эту серию, удачно сочетают в себе детективный сюжет и элементы мистики, философии, истории и религии, что сделало их прекрасными объектами для экранизации. Они полны интриг и загадок, связанных с историей становления христианства, крестовыми походами, мальтийским орденом и тамплиерам ...
Серия: Книга-загадка, книга-бестселлер
Формат: FB2, OCR без ошибок
Автор: разные
Год выпуска: 2012-2016
Жанр: Интеллектуальная проза, детектив, триллер
Издательство: Эксмо
Язык: русский
Количество книг: 211
Описание: "Книга-загадка, книга-бестселлер" Романы, вошедшие в эту серию, удачно сочетают в себе детективный сюжет и элементы мистики, философии, истории и религии, что сделало их прекрасными объектами для экранизации. Они полны интриг и загадок, связанных с историей становления христианства, крестовыми походами, мальтийским орденом и тамплиерам ...
10
янв
2014
янв
2014
Книга шипов и огня. 1-я книга серии "Книга шипов и огня" (Рэй Карсон) [2013, Фэнтези, FB2, OCR без ошибок]

ISBN: 978-5-17-080449-8
Формат: FB2, OCR без ошибок
Автор: Рэй Карсон
Год выпуска: 2013
Издательство: АСТ
Жанр: Фэнтези
Язык: Русский
Количество страниц: 512
Описание: С самого детства Элизе уготован особый путь. Она не только принцесса Оровале, но и избранная на служение высшими силами. Как гласит священный текст, раз в столетие Божественный камень выбирает себе носителя, которому суждено совершить нечто великое. Только вот Элиза совсем не чувствует себя готовой ни к каким свершениям. Ей шестнадцать, она толстая и некрасивая, у нее нет друзей, и она должна стать тайной супругой короля Алехан ...
Формат: FB2, OCR без ошибок
Автор: Рэй Карсон
Год выпуска: 2013
Издательство: АСТ
Жанр: Фэнтези
Язык: Русский
Количество страниц: 512
Описание: С самого детства Элизе уготован особый путь. Она не только принцесса Оровале, но и избранная на служение высшими силами. Как гласит священный текст, раз в столетие Божественный камень выбирает себе носителя, которому суждено совершить нечто великое. Только вот Элиза совсем не чувствует себя готовой ни к каким свершениям. Ей шестнадцать, она толстая и некрасивая, у нее нет друзей, и она должна стать тайной супругой короля Алехан ...








